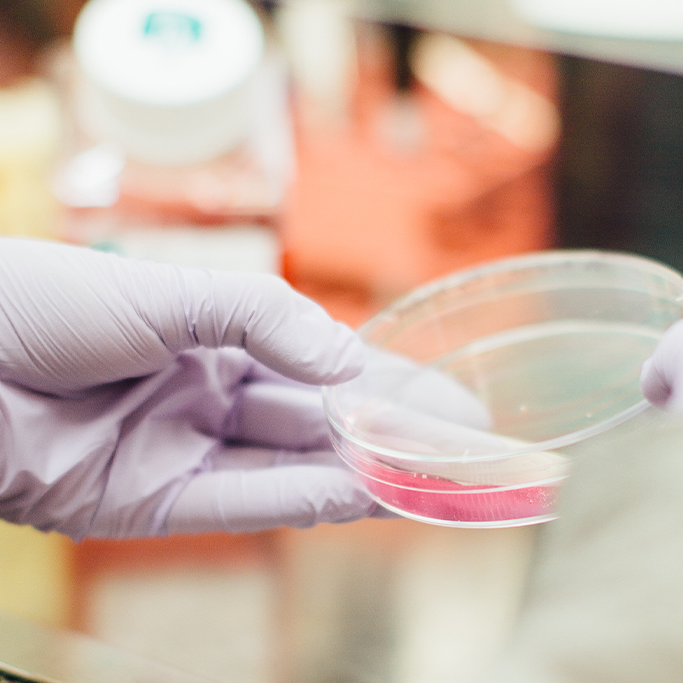
Gloved hands tilting a petri dish with pink liquid

Fundamental sciences research strengths
Fundamental sciences are the disciplines that support all scientific and systematic research, from microbiology and genome systems to data science and astrophysics. Our faculty conducts world-class research in numerous areas of fundamental sciences. Explore our specialisations below.

Astrophysics
Astrophysics is a branch of science that applies the laws of physics and chemistry to explain the lifecycle of stars, planets and galaxies in the universe, and how the universe has changed with time. Astrophysicists also use data science to analyse the huge observational data sets that are now available.
Astrophysics is one of the major research areas of the UNSW School of Physics and has research strengths in:
- Antarctic astronomy
- chemistry and dynamics of the interstellar medium
- cosmology
- exoplanetary science
- galactic archaeology
- galaxy evolution
- stellar astrophysics.

Chemistry
The UNSW School of Chemistry carries out a wide range of research across a variety of chemical disciplines. Each research project can be aligned with one or more of three main research themes or clusters in the school:
- catalysis and energy - research into energy generation, storage and usage is needed to deliver solutions that will allow a growing global population to share in the technological advances of the industrial era
- nanoscience - the fabrication of new materials using molecular scale building blocks is one of the fundamental principles of nanoscience
- medicinal chemistry - the need for new therapeutics and drugs is greater than ever.

Cognitive sciences
The cognitive sciences explore how the brain takes in information about the world, how it represents information about the world and how it uses it. Through elegant experiments, cognitive scientists have learned a lot about how perception, attention and memory work.
Areas of student interest include:
- psychology
- cognitive science
- data analysis.

Evolutionary biology
Evolutionary biology is the study of organismal adaptation over short and long-time scales. Evolutionary biology research in UNSW Science strives to understand biological diversities and phenomena in the natural world in the light of evolutionary theory.
The Evolution & Ecology Research Centre’s areas of study in evolutionary biology include:
- behavioural ecology and animal behaviour
- evolutionary ecology
- evolutionary genetics and epigenetics
- animal and human mate choice
- natural and sexual selection
- natural and life history
- plan and animal evolution.
The Evolution & Ecology Research Centre draws together the diverse strengths of over 50 academic staff and independent research fellows, and over 60 postgraduate students mainly from the School of Biological, Earth & Environmental Sciences, but also from the School of Biotechnology & Biomolecular Sciences, School of Mathematics & Statistics and the School of Economics & Humanities & Languages.

Genome & systems biology
Our genome and systems biology research adopts a holistic approach to build in-depth profiles, molecular roadmaps and mathematical models of the cell. This is so we can better understand how life is organised and how it changes during development, ageing, disease and in response to the environment.
With ties to biotechnology, pharmaceutical and chemical industries, the UNSW School of Biotechnology & Biomolecular Sciences encourages collaborative research. We foster an environment of discovery for students and researchers to use advanced omics techniques such as mass spectrometry and next-generation sequencing.
We also host the Ramaciotti Centre for Genomics, the largest genomics facility at any Australian University.

Mathematical & statistical modelling
Modelling is a simplified, mathematically formalised way to approximate reality. Mathematical modelling translates real-world problems into tractable mathematical formulations. Theoretical and numerical analyses provide insight, answers and guidance useful for the application. Mathematical modelling is indispensable in many areas.
The model provides an abstraction that reduces a problem to its essential characteristics. The models are fitted to data, identifying the possible processes underlying the particular phenomenon. Statistical modelling combines inferences based on collected data and populations to understand and predict information in an idealised form.
Descriptive statistics abstracts data sets, reducing the complexity to understand the trends underlying the data. Inferential statistics tests hypotheses about data.
The UNSW School of Mathematics & Statistics specialises in areas of modelling such as:
- biomathematics and biostatistics (modelling of biological systems and biomedicine)
- ecology
- fluid dynamics
- oceanic and atmospheric sciences
- finance and risk analysis.

Mathematics
Mathematics and statistics are fundamental to all sciences and reach across all areas of human endeavour.
Research in mathematics and statistics in the UNSW Faculty of Science covers all areas from pure abstractions through to transformative real-world applications.
Specialisations include:
- biomathematics
- computational mathematics
- ocean and atmosphere sciences
- optimisation
- algebra
- combinatorics
- functional and harmonic analysis
- geometry
- mathematical physics
- number theory
- Bayesian methods
- Monte Carlo methods
- biostatistics
- ecology
- finance and risk
- stochastic analysis
- fractional calculus.

Meta-analysis
Meta-analysis is a research synthesis method to reveal the robustness and generality of research findings. Researchers in UNSW Science have developed methodologies for meta-analysis. For example, the Evolution & Ecology Research Centre uses meta-analyses to study:
- evolutionary biology
- ecology
- climate change
- marine biology
- meta-science and meta-research.

Microbiology
The School of Biotechnology & Biomolecular Sciences is a powerhouse of biomolecular research and training with over 150 higher degrees by research students. Our school employs 35 academics, more than 20 research associates and 15 professional and technical staff.
We consistently attract government and industry funding and top-tier academic accolades.
Our research is grouped into three clusters:
- genomics and bioinformatics - specialises in the evolution, structure and editing of genomes. The Ramaciotti Centre for Genomics is the largest genomics facility at any Australian university
- microbiology and microbiomes - explores the importance of microbes in the environment and microbial contributions to health and disease
- molecular and cell biology - incorporating molecular genetics, stem cell biology, microscopy, computer science and epidemiology.

Molecular & cell biology
Recent advances in molecular and cell biology, especially the continuing development of recombinant DNA technology, have revolutionised our understanding of the structure, function and regulation of individual genes. These advances have opened the exciting field of molecular biology: one of the most rapidly growing areas in biology.
This marriage of biochemistry, microbiology and cell biology provides an exciting new approach for the study of all living organisms, including humans.
We're committed to high quality research training and employ many postdoctoral researchers on a wide variety of grants and research projects.

Optimisation
Optimisation bridges fundamental mathematical and applied data sciences. Research in optimisation includes model development, analysis, numerical techniques and applications.
Optimisation is about finding the 'best' way to do a task, subject to any restrictions. Optimisation is ubiquitous and critical to the modern world with everything from the navigation that gets us from A to B, logistics that get groceries to shelves and to the delivery of life-saving medicine being underpinned by optimisation.
Special research strengths in optimisation at UNSW include:
- non-linear programming
- non-smooth analysis and optimisation
- global optimisation
- applied non-linear functional analysis
- semi-definite programming
- optimal control for cancer chemotherapy
- numerical methods for non-smooth problems
- integer programming
- stochastic programming
- robust optimisation.

Physics
The UNSW School of Physics is well positioned to play its role as a leading centre of research excellence. The school has received an average of 18 million dollars a year in external research funding and published an average of 160 refereed papers a year over the last five years.
Physics research at UNSW is currently divided into four broad areas:
- astrophysics - research specialisations include exoplanetary science, galactic archaeology, galaxy evolution and stellar astrophysics
- biophysics - biochemistry, nanotechnology, bioengineering, computational biology and (complex) systems biology
- condensed matter physics and quantum computing - electrical, optical, magnetic and thermal properties of advanced nanoscale materials, with applications in nanoelectronics, computing, memory elements, energy and biotechnology
- theoretical physics - endeavours to improve our analytic understanding of the universe from the smallest to the largest scales.
